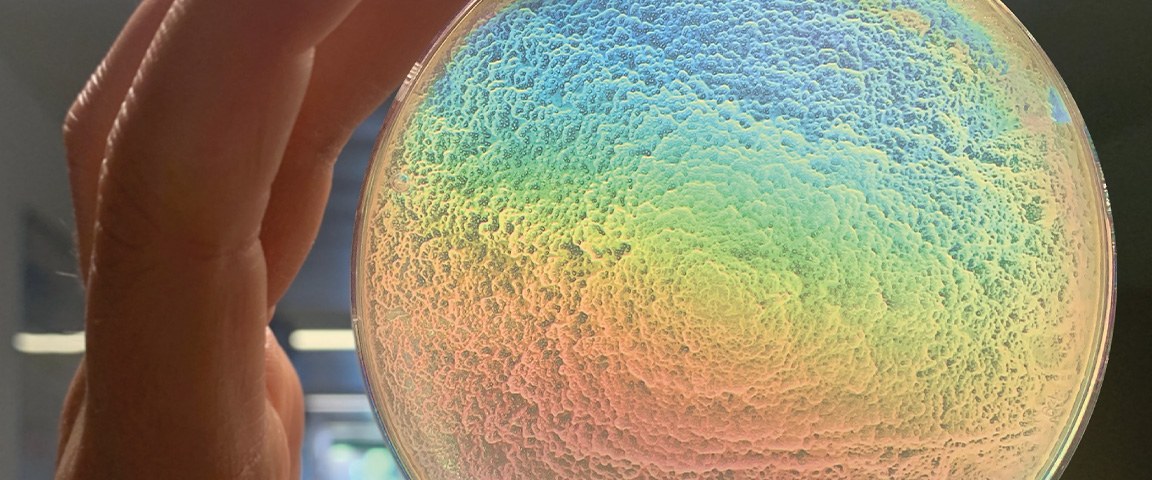

Insights Into the Metabolism of Plastic-Eating Bacteria
14 December 2023
Plastic-eating bacteria could help to curb the global waste problem in the future. But many questions remain unanswered. Researchers at Forschungszentrum Jülich and Heinrich Heine University Düsseldorf have now shown for the first time how bacteria of the genus Halopseudomonas break down common plastic coatings made of polyester urethane. The metabolic pathways and enzymes described underline the relevance of the newly isolated bacterium for the biodegradation of plastics and pave the way for its application.
Plastic materials are indispensable in everyday life. But if they are left lying around, they become a problem. As they do not decompose, they accumulate in the environment, a process that has already led to global pollution. Only recently, a promising candidate was discovered – bacteria of the genus Halopseudomonas. Researchers at Forschungszentrum Jülich and Heinrich Heine University Düsseldorf have now taken a closer look at these bacteria. The results have been published in two joint articles in the journal Microbial Biotechnology.
Halopseudomonas bacteria live in the deep sea in places that are polluted with crude oil or heavy metals. However, they have also been found in compost heaps. Researchers from Jülich and Düsseldorf have now discovered that the bacteria have a particular appetite for so-called polyester polyurethanes. This type of plastic is used to coat textiles, ropes and fishing nets, among other things, which improves their durability but at the same time makes it more difficult to break down or recycle these plastic materials.
One promising solution of this problem lies with the bacterium Halopseudomonas formosensis FZJ, which was isolated from a compost heap. The bacteria can rapidly biodegrade polyester urethane coatings and is particularly tolerant of the high temperatures that typically occur in compost.
Researchers led by Prof. Nick Wierckx from the Institute of Bio- and Geosciences (IBG-1) at Forschungszentrum Jülich have succeeded in elucidating the metabolic pathways underlying this process. In the paper by Jan de Witt et al., they also describe an enzyme involved in the coating degradation.
Pathways to biotechnological application
Researchers at the Institute for Molecular Enzyme Technology at HHU Düsseldorf led by Prof. Karl-Erich Jaeger have investigated further steps towards practical implementation. In the paper by Luzie Kruse et al. they further unlock Halopseudomonas bacteria for biotechnology applications by developing appropriate cultivation strategies and molecular biological methods allowing for genetic modification of these bacteria. It is also shown that these bacteria can utilize dicarboxylic acids, which are components of many plastics.
"These two publications provide detailed insights into the microbial degradation of plastics and underlines the importance of the newly isolated bacterium for future processes enabling plastic biodegradation and bio-upcycling", Nick Wierckx and Karl-Erich Jaeger agree.
This work arose from a fruitful collaboration between the HHU Institute of Molecular Enzyme Technology IMET led by Jaeger and the research group "Microbial Catalysis" led by Wierckx at the Jülich Institute of Bio- and Geosciences IBG-1. The work in the Wierckx group was funded by the EU Horizon 2020 project Glaukos, the work in the Jaeger group by the BMBF projects No-Stress and PlastiSea. The plastic coatings were provided by industry partners I-Coats and Covestro. The close collaboration between the IBG-1 and IMET teams with industry partners thus paves the way for potential applications in biotechnology and bioremediation.
Original publications
Kruse, L., Loeschcke, A., Witt, J. de, Wierckx, N., Jaeger, K.-E., Thies, S.
Halopseudomonas species: Cultivation and molecular genetic tools
Microb. Biotechnol. (2023), DOI: 10.1111/1751-7915.14369
de Witt, J., Molitor, R., Gätgens, J., Ortmann de Percin Northumberland, C., Kruse, L., Polen, T., Wynands, B., van Goethem, K., Thies, S., Jaeger, K.-E., Wierckx, N. (2023). Biodegradation of poly(ester-urethane) coatings by Halopseudomonas formosensis. Microb. Biotechnol. DOI: 10.1111/1751-7915.14362
Contact
Press Contact
Funded projects
No-Stress | BMBF program "Microbial Biofactories", funding code: 031B0852 |
|---|---|
Glaukos | This project has received funding from the Bio-based Industries Joint Undertaking (JU) under the European Union’s Horizon 2020 research and innovation programme under grant agreement No 887711. The JU receives support from the European Union’s Horizon 2020 research and innovation programme and the Bio-based Industries Consortium. |
PlastiSea | BMBF program "New biotechnological processes based on marine resources - BioProMare", funding code: 161B0867D |